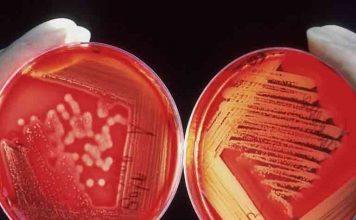
Ο λόγος που ο Candida Auris τρομάζει πολύ περισσότερο απ’ τον κορωνοϊό

Ισπανία: Σχολείο στην ακρογιαλιά
Σχολείο στη θάλασσα, ένα σχολείο στην ισπανική περιοχή της Μούρθια κάνει ακριβώς αυτό, προσπαθώντας να συνδυάσει τον καθαρό αέρα και έναν νέο τρόπο διδασκαλίας, μετά...
Τζόνας Σολκ – η επιστήμη στην υπηρεσία του Ανθρώπου
Μέχρι το 1955, όταν παρουσίαστηκε το εμβόλιο Σολκ, η πολιομυελίτιδα θεωρούνταν στις μεταπολεμικές Η.Π.Α. ο τρομακτικότερος κίνδυνος για τη δημόσια υγεία. Τα ετήσια κρούσματα αυξάνονταν με...
«Αστέρι της Βηθλεέμ» 21/12: Μοναδικό φαινόμενο από τη σύνοδο Δία και Κρόνου
Οι δύο μεγαλύτεροι πλανήτες στο ηλιακό σύστημα, ο Δίας και ο Κρόνος, θα εμφανιστούν πιο κοντά ο ένας στον άλλο στο νυχτερινό ουρανό κατά...
Χαλυβουργείο Salzgitter (Salzgitter Flachstahl)
Ένα απόγευμα στα τέλη του περασμένου Μάη με παίρνει τηλέφωνο ο Χρήστος και μου λέει «πάμε για ένα ουζάκι;» «Μέσα» λέω, «αλλά εγώ θα...
Τα κατοικίδια ζώα «όπλα» κατά της μοναξιάς στην εποχή του Covid-19
Η λαχτάρα της αφής. Στην εποχή της κοινωνικής απόστασης, για κάποιους ανθρώπους τα κατοικίδια ζώα μπορεί να είναι τα μόνα ζωντανά πλάσματα, τα οποία...
Πώς δρα το επαναστατικό φάρμακο που σκοτώνει τους καρκινικούς όγκους
Επιστήμονες του City of Hope, ενός από τους μεγαλύτερους οργανισμούς έρευνας και θεραπείας του καρκίνου στις ΗΠΑ, εφηύραν ένα νέο φάρμακο, το οποίο δίνει ελπίδα σε όλους όσους...
Παρατηρητήριο Διεθνών Οργανισμών και Παγκοσμιοποίησης: Στοπ στο πόλεμο!
Ως κίνηση ειρήνης, μέλος του Διεθνούς Γραφείου Ειρήνης (ΙΡΒ), το Παρατηρητήριο Διεθνών Οργανισμών και Παγκοσμιοποίησης (ΠΑΔΟΠ) εκφράζει την οργή του για την στρατιωτική επιδρομή...
Μπαρ στο Ισραήλ κερνάει ποτά όσους εμβολιάζονται πριν την είσοδο!
Mπαρ στο Τελ Αβίβ του Ισραήλ μετατράπηκε σε ένα πρωτότυπο κέντρο εμβολιασμού, προσφέροντας εμβόλια για τον κορωνοϊό και δωρεάν ποτά.
Σε μια προσπάθεια να ενθαρρύνουν...
Πάνω από 5.500 γυναίκες & μικρά κορίτσια εξαφανίστηκαν εν μέσω πανδημίας στο Περού
Έκθεση του Συνηγόρου του Λαού με τίτλο «Qué pasó con ellas?» καταγράφει διπλασιασμό των εξαφανίσεων που συνδέονται με την έμφυλη βία και την εμπορία...
“Eco-Fest 2020’’ – πράσινες πόλεις, βιώσιμη ανάπτυξη και ηλεκτροκίνηση
Στις 18, 19 & 20 Ιανουαρίου 2020, στην Τεχνόπολη στο Γκάζι, θα πραγματοποιηθεί το “Eco-Fest 2020’', το οποίο είναι αφιερωμένο στις πράσινες πόλεις, τη...